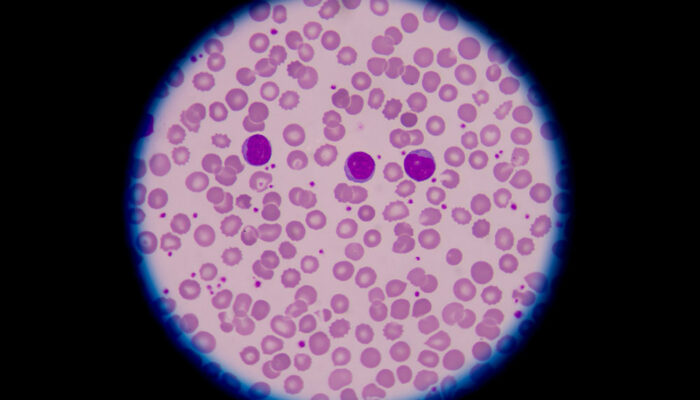
Everything you need to know about blood disorders

Understanding treatment options for allergies
Allergies are a common problem, and there is nothing that can be done to avoid them. However, there are treatments and medications available that help manage the symptoms caused due to an allergic reaction. It is necessary to be aware of the course of action in case you or someone around you is suddenly experiencing an allergic reaction. Continue reading to learn more about allergies, how to detect them, and its treatment options. What are allergies and how to detect them? An allergy is the reaction produced by the immune system when it is trying to fight a foreign substance it believes to be harmful. This foreign substance does not have to be bacteria or viruses. Sometimes, your immune system fights virtually non-harmful substances such as grass, dust mites, dander, and food, assuming them as harmful. This reaction against non-harmful substances or “allergens” is known as an allergic reaction. The body reacts to different things on a different scale. That means the type, the severity, and the signs of an allergic reaction can differ from person to person. While our genetics do play a role in their manifestation, it does not necessarily mean we exhibit the same allergies as our parents.
Read More